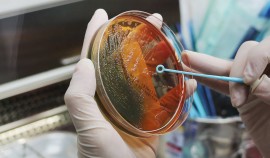
В России выявили вид бактерий активных против коронавируса

Смотреть эфир
15:45 «Ислам и жизнь»
16:00 «Новости» Информационная программа
16:25 «Вестник профсоюза образования» Вестник профсоюза
пт